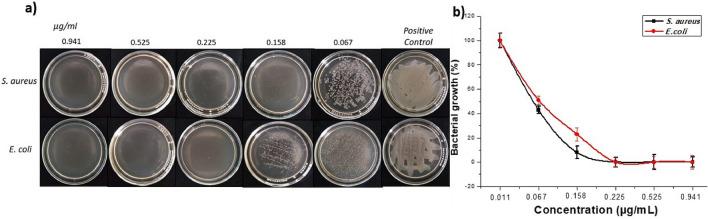
https://cdn.ncbi.nlm.nih.gov/pmc/blobs/120d/9842608/8a241114fd01/41598_2022_26818_Fig4_HTML.jpg

从 Cuphea procumbens 生物生成银纳米颗粒,用于生物医学和环境应用。
Biogeneration of silver nanoparticles from Cuphea procumbens for biomedical and environmental applications.
机构信息
Departamento de Biotecnología, Facultad de Ciencias, Universidad Autónoma del Estado de México (UAEMex), 50200, Toluca, Mexico.
Facultad de Química, Universidad Autónoma del Estado de México (UAEMex), 50200, Toluca, Mexico.
出版信息
Sci Rep. 2023 Jan 16;13(1):790. doi: 10.1038/s41598-022-26818-3.
Nanotechnology is one of the most important and relevant disciplines today due to the specific electrical, optical, magnetic, chemical, mechanical and biomedical properties of nanoparticles. In the present study we demonstrate the efficacy of Cuphea procumbens to biogenerate silver nanoparticles (AgNPs) with antibacterial and antitumor activity. These nanoparticles were synthesized using the aqueous extract of C. procumbens as reducing agent and silver nitrate as oxidizing agent. The Transmission Electron Microscopy demonstrated that the biogenic AgNPs were predominantly quasi-spherical with an average particle size of 23.45 nm. The surface plasmonic resonance was analyzed by ultraviolet visible spectroscopy (UV-Vis) observing a maximum absorption band at 441 nm and Infrared Spectroscopy (FT IR) was used in order to structurally identify the functional groups of some compounds involved in the formation of nanoparticles. The AgNPs demonstrated to have antibacterial activity against the pathogenic bacteria Escherichia coli and Staphylococcus aureus, identifying the maximum zone of inhibition at the concentration of 0.225 and 0.158 µg/mL respectively. Moreover, compared to the extract, AgNPs exhibited better antitumor activity and higher therapeutic index (TI) against several tumor cell lines such as human breast carcinoma MCF-7 (IC of 2.56 µg/mL, TI of 27.65 µg/mL), MDA-MB-468 (IC of 2.25 µg/mL, TI of 31.53 µg/mL), human colon carcinoma HCT-116 (IC of 1.38 µg/mL, TI of 51.07 µg/mL) and melanoma A-375 (IC of 6.51 µg/mL, TI of 10.89 µg/mL). This fact is of great since it will reduce the side effects derived from the treatment. In addition, AgNPs revealed to have a photocatalytic activity of the dyes congo red (10 M) in 5 min and malachite green (10 M) in 7 min. Additionally, the degradation percentages were obtained, which were 86.61% for congo red and 82.11% for malachite green. Overall, our results demonstrated for the first time that C. procumbens biogenerated nanoparticles are excellent candidates for several biomedical and environmental applications.
纳米技术是当今最重要和最相关的学科之一,因为纳米粒子具有特定的电学、光学、磁学、化学、机械和生物医学性质。在本研究中,我们证明了 Cuphea procumbens 能够生物合成具有抗菌和抗肿瘤活性的银纳米粒子(AgNPs)。这些纳米粒子是使用 Cuphea procumbens 的水提取物作为还原剂和硝酸银作为氧化剂合成的。透射电子显微镜显示,生物合成的 AgNPs 主要为类球形,平均粒径为 23.45nm。通过紫外可见光谱(UV-Vis)分析表面等离子体共振,观察到 441nm 处的最大吸收带,并用红外光谱(FTIR)对参与纳米粒子形成的某些化合物的功能基团进行结构鉴定。AgNPs 对致病性细菌大肠杆菌和金黄色葡萄球菌具有抗菌活性,在浓度为 0.225 和 0.158μg/mL 时分别鉴定出最大抑菌圈。此外,与提取物相比,AgNPs 对几种肿瘤细胞系(如人乳腺癌 MCF-7(IC 为 2.56μg/mL,TI 为 27.65μg/mL)、MDA-MB-468(IC 为 2.25μg/mL,TI 为 31.53μg/mL)、人结肠癌细胞 HCT-116(IC 为 1.38μg/mL,TI 为 51.07μg/mL)和黑色素瘤 A-375(IC 为 6.51μg/mL,TI 为 10.89μg/mL)具有更好的抗肿瘤活性和更高的治疗指数(TI)。这一事实非常重要,因为它将减少治疗带来的副作用。此外,AgNPs 对刚果红(10μM)在 5 分钟内和孔雀石绿(10μM)在 7 分钟内显示出光催化染料的活性。此外,还获得了降解百分比,刚果红为 86.61%,孔雀石绿为 82.11%。总的来说,我们的结果首次证明,Cuphea procumbens 生物合成的纳米粒子是几种生物医学和环境应用的优秀候选物。